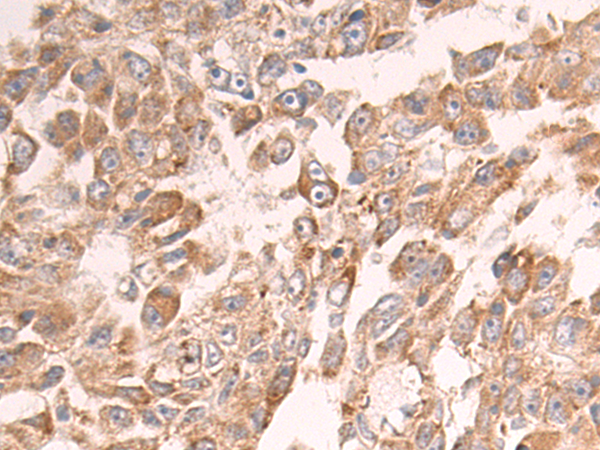

-
分类: 科研抗体货号: P10061别名: Ntra; KILON; IGLON4; DMML2433应用: WB,IHC反应种属: Human, Mouse, Rat
-
分类: 科研抗体货号: P10076别名: CRCS1; GalNAc-T12应用: IHC反应种属: Human, Mouse
-
分类: 科研抗体货号: P10044别名: ARL6; ARF4L应用: IHC反应种属: Human, Mouse
-
分类: 科研抗体货号: P10075别名: MLS; CCHL; MCOPS7; LSDMCA1应用: WB,IHC反应种属: Human, Mouse
-
分类: 科研抗体货号: P10060别名: GST; GST13; hGSTK1; GSTK1-1; GST13-13; GST 13-13应用: WB,IHC反应种属: Human
-
分类: 科研抗体货号: P10043别名: HC7-I应用: WB,IHC反应种属: Human, Mouse, Rat
-
分类: 科研抗体货号: P10074别名: hMLKL应用: IHC反应种属: Human
-
分类: 科研抗体货号: P10059别名: Msl1; U2B''应用: WB,IHC反应种属: Human, Mouse
-
分类: 科研抗体货号: P10040别名:应用: IHC反应种属: Human, Mouse
-
分类: 科研抗体货号: P10073别名: NST; BRSTL1; SULTX3; BR-STL-1; DJ388M5.3; hBR-STL-1应用: IHC反应种属: Human, Mouse, Rat

鄂公网安备42018502007531号
鄂公网安备42018502007531号

